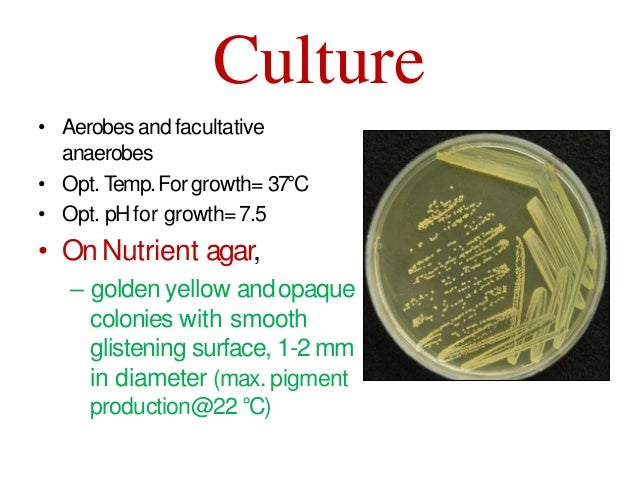
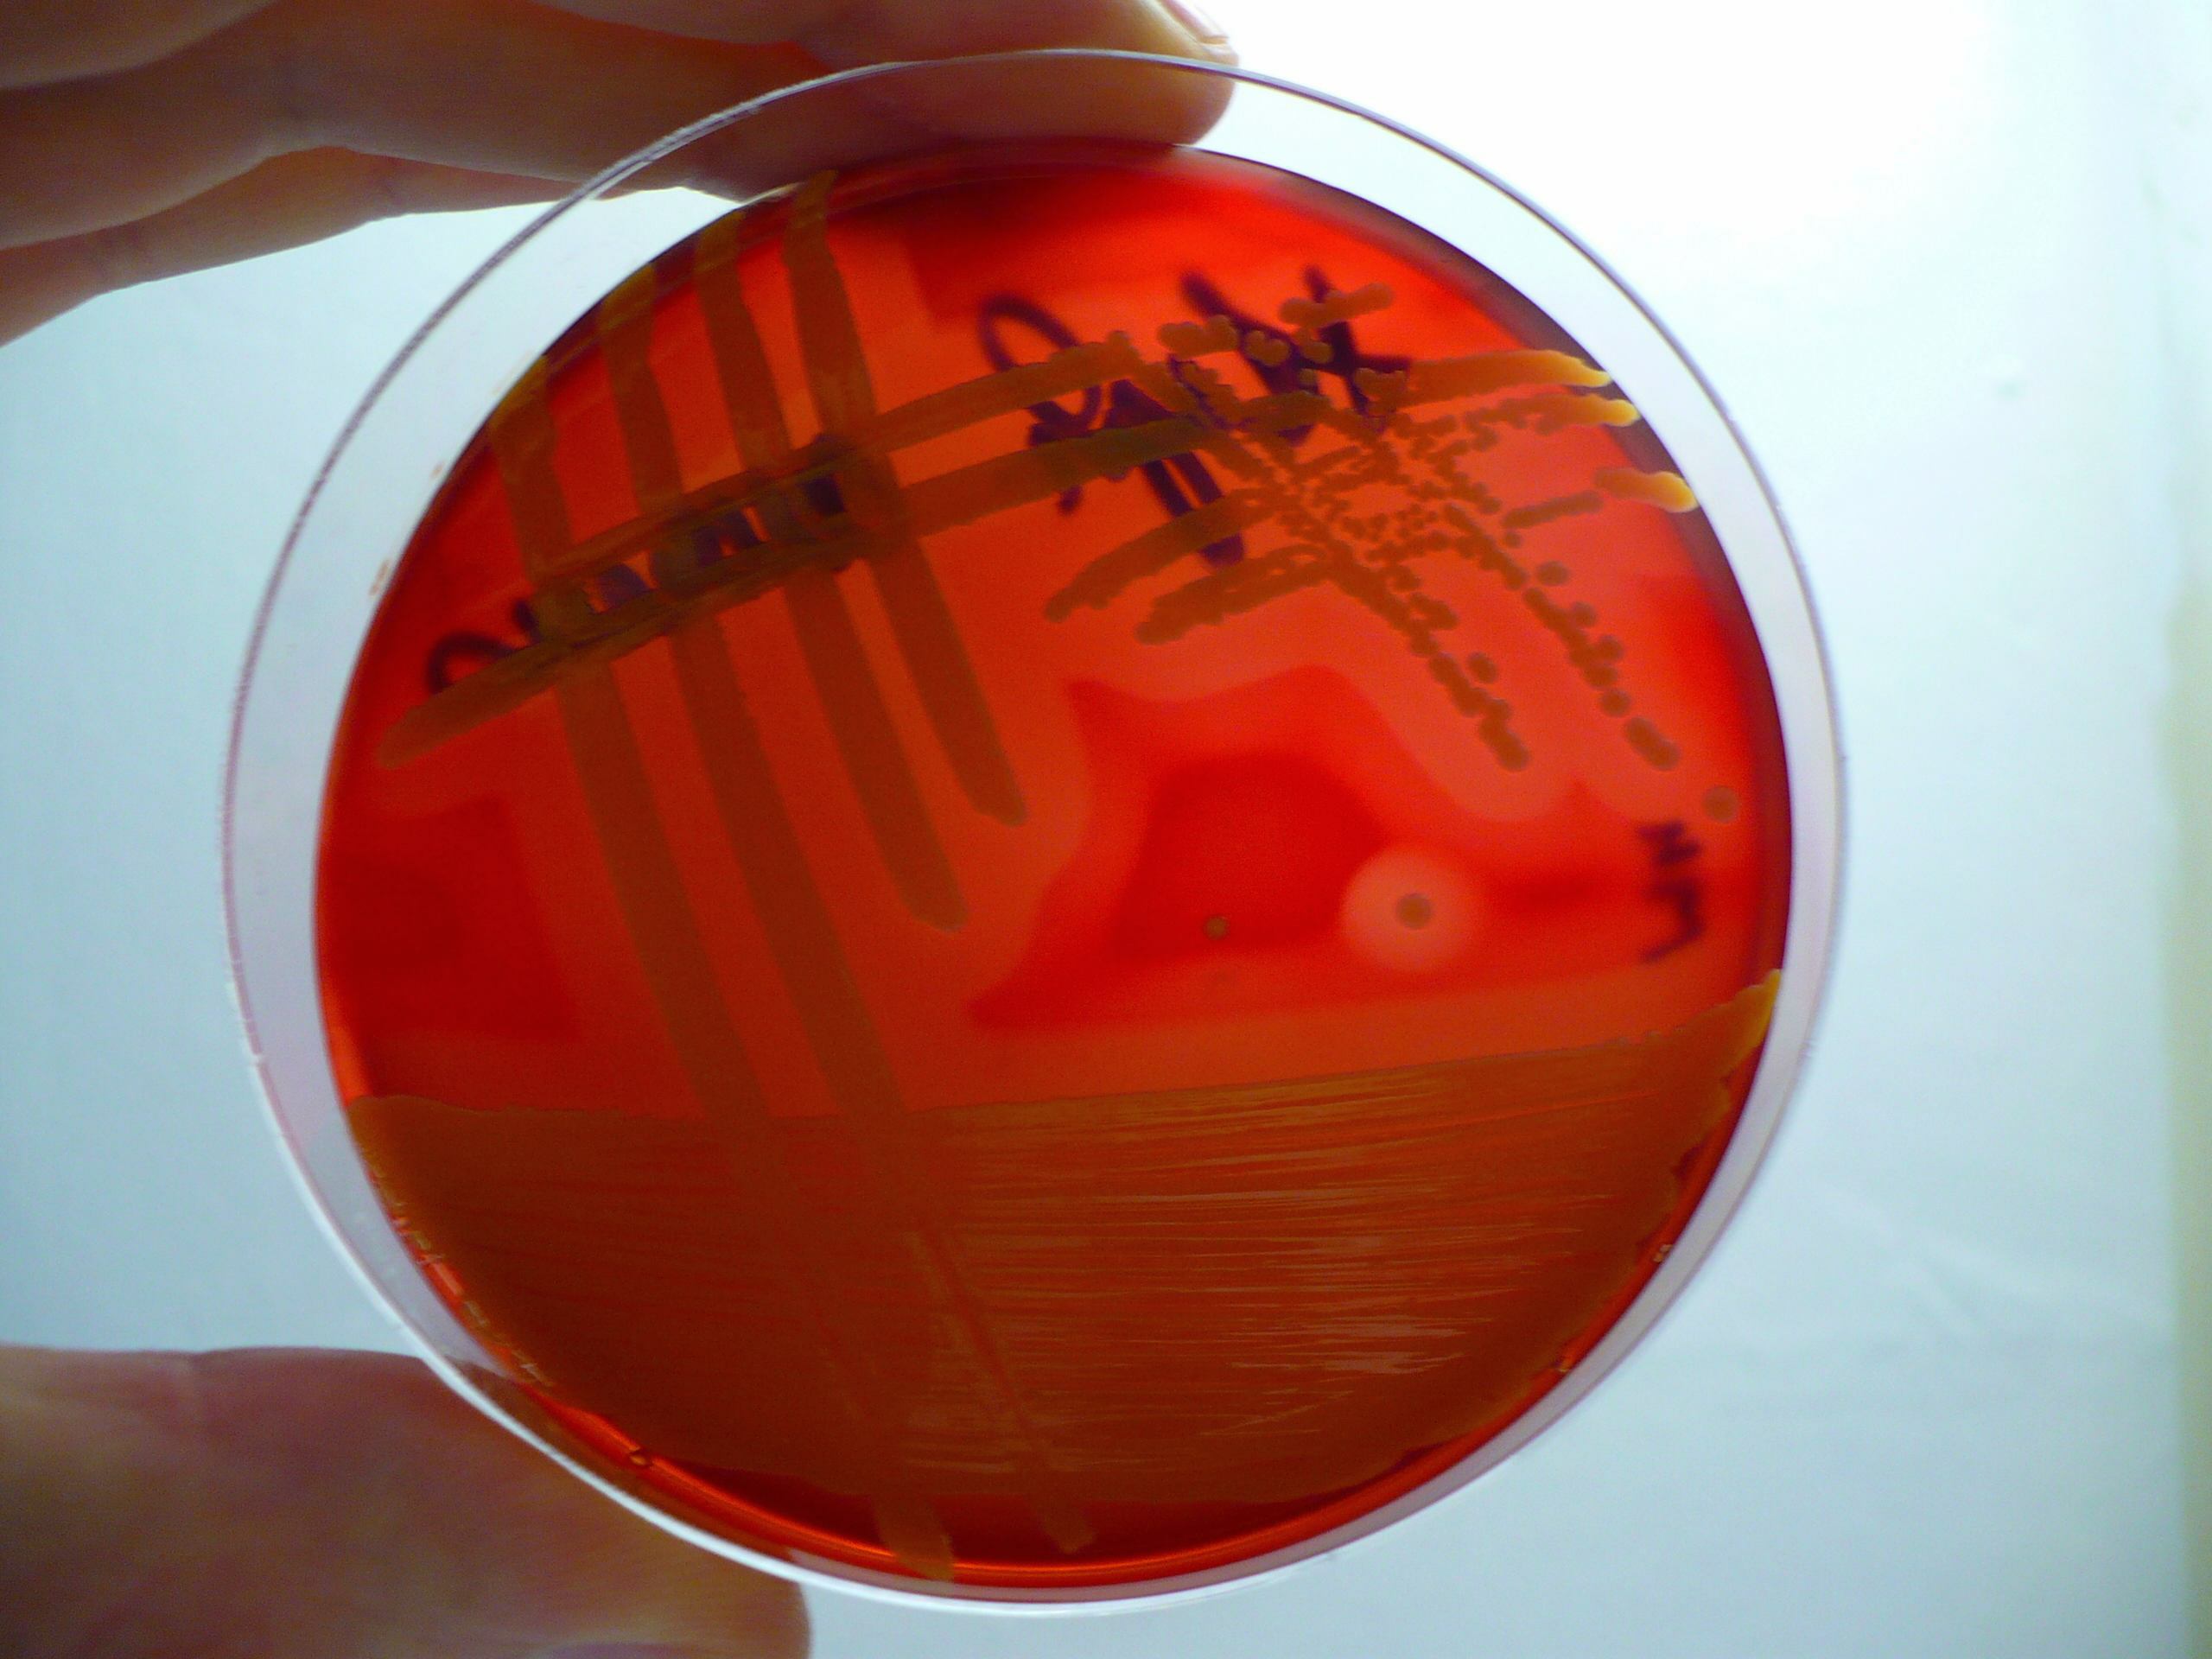

Фотографии и описание стафилококка хромогенеса в микробиологии

Раздел: Другие животные